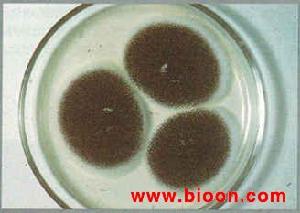
耳真菌病

疾病名稱
 耳真菌病
耳真菌病耳真菌病
疾病分類
皮膚性病科,耳鼻喉科
病因
病的真菌種類甚多,以曲黴菌、青黴菌及念致珠菌等引起者較常見;游泳、沐浴、中耳流膿、而內滴入各種抗菌藥液、挖耳損傷等均為重要誘發因素。
疾病概述
外耳道真菌病是外耳道的真菌感染性疾病。當外耳道進水或積極存分泌物、常滴用抗生素液等情況下、較易受真菌感染,常見有青黴素、麴黴菌及白色念珠菌等。
症狀:耳內發癢,有的感奇癢,以夜間為甚。檢查見外耳道和鼓覆蓋有黃色或白色粉末狀或絨毛狀苔膜,有時分泌物或痂皮呈筒狀,除去後見患處略充血潮濕。
檢查:將清除下的痂皮作塗片,於顯微鏡下可查見菌絲和孢子。
治療:清除外耳道內的所有痂皮和分泌物,用1~2%柳酸酒精或1~2%麝香草酚酒精、1:1000新潔爾滅酒精塗耳。也可用制黴菌素噴於外耳道或塗用達克寧霜劑。儘量保持外耳道乾燥
疾病描述
耳真菌病多局限於外耳、侵入中耳者極少,
耳真菌病
耳真菌病體徵
早期或輕者可無症狀,。一般均有耳內發癢及悶脹感。有少量水樣分泌無,待因炎症而致外耳道表皮脫落,與菌絲體共同形成痂皮,阻塞外耳道或覆於鼓膜表面時,則可出現聽力減退及耳鳴。若有細菌感染而致上皮下層受累時,則可引起腫脹、疼痛及流膿。
生理
病的真菌種類甚多,以麴黴菌、青黴菌及念致珠菌等引起者較常見;游泳、沐浴、中耳流膿、而內滴入各種抗菌藥液、挖耳損傷等均為重要誘發因素。
診斷檢查
檢查所見可因真菌種類及病變程度而異,常見外耳道深部有白色、灰色、黃色或煙黑色霉苔,其狀如薄膜或冬粉。甚似發霉一樣,有時呈簡、塊狀。揭去苔膜後,可見外耳道皮膚充血、腫脹、表現輕度糜爛、或有少量滲血、將霉苔置於載玻片上,滴少許10%氫氧化鉀溶液,蓋妥並適當加溫,若於顯微鏡下見到菌絲體或芽胞狀物,即可明確診斷。
治療方案
首應清除外耳道蘚膜或筒、塊狀物,拭乾創面,局部可塗擦或滴用2%龍膽紫酒精,3%水楊酸酒精,1%麝香草酚酒精、2%蘚珠酸酒精等,亦可噴用制黴菌素硼酸粉。
預防
保持外耳道乾燥、勿用不潔之物挖耳、水入耳後及時拭淨並滴入酒精,合理使用抗生素及激素等。
保健貼士
1、避免刺激性的藥物點耳及用不清潔的物品挖耳。尤其在耳內進水後應將耳內儘快擦乾。如長期耳內潮濕易引起黴菌感染;
2、清除外耳道內的所有痂皮和分泌物,用1~2%柳酸酒精或1~2%麝香草酚酒精塗耳。也可用制黴菌素噴於外耳道或塗用達克寧霜劑。儘量保持外耳道乾燥。

